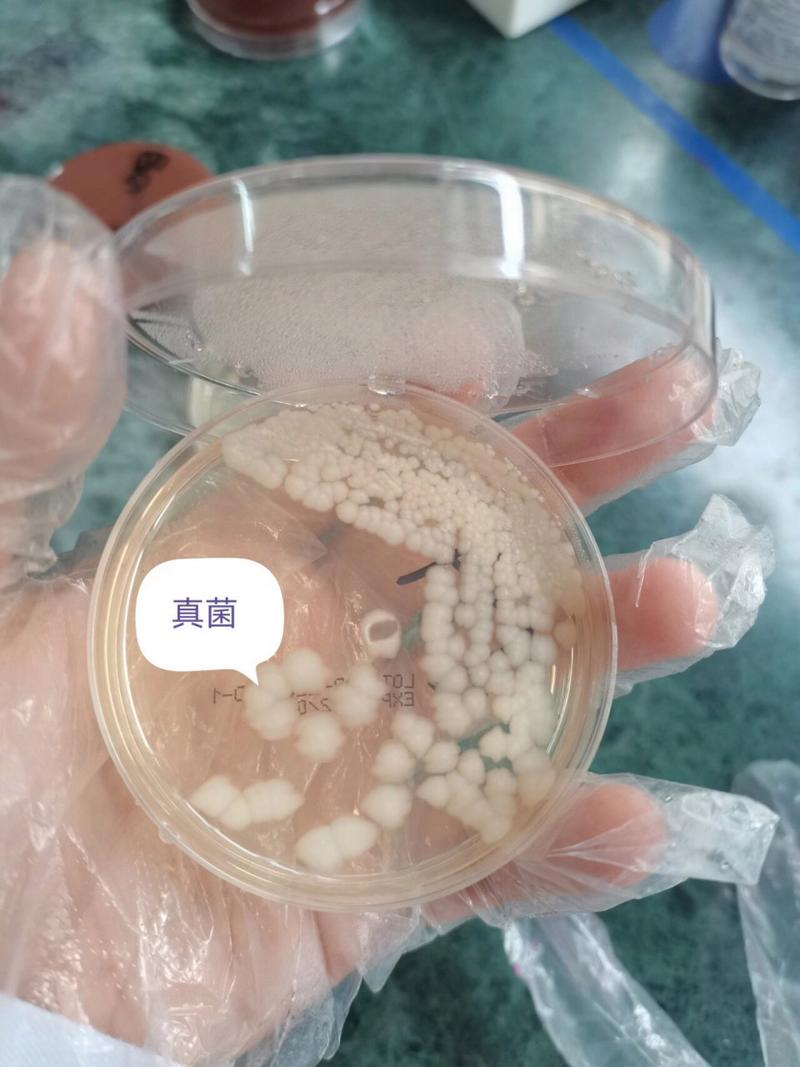

商品介绍
商品简介
内生真菌被定义为生活史中特定阶段存在于健康植物组织内,通过互惠共生关系获取营养但不会引发宿主明显病理症状的真菌类群 [3]。按功能特性可分为:促生型:分泌吲哚乙酸(IAA)促进植物生长,如苹果内生粉红粘帚霉 [5]防御型:产生抗菌物质抵御病原体,如苦参菌株BS001抑制16种致病菌 [6]代谢型:合成特殊次生代谢物,如蛇足石杉菌株产新型生物碱 [4]
商品详情
内生真菌被定义为生活史中特定阶段存在于健康植物组织内,通过互惠共生关系获取营养但不会引发宿主明显病理症状的真菌类群 [3]。按功能特性可分为:促生型:分泌吲哚乙酸(IAA)促进植物生长,如苹果内生粉红粘帚霉 [5]防御型:产生抗菌物质抵御病原体,如苦参菌株BS001抑制16种致病菌 [6]代谢型:合成特殊次生代谢物,如蛇足石杉菌株产新型生物碱 [4]
东平农产品基地
农产品产业集群
广东省广州市 西湖
2016-10-27 08:46:25
| 物料名称 | 物料溯源 |
|---|
| 溯源属性 | 属性内容 | 单位 |
|---|---|---|
| 土壤-排水性 | 良好 | |
| 灌溉水质等级 | Ⅰ类 | |
| 肥料类型 | 有机肥 | |
| 收割方式 | 人工 | |
| 运输类型 | 种植基地到工厂 | |
| 运输方式 | 普通运输 |
发送